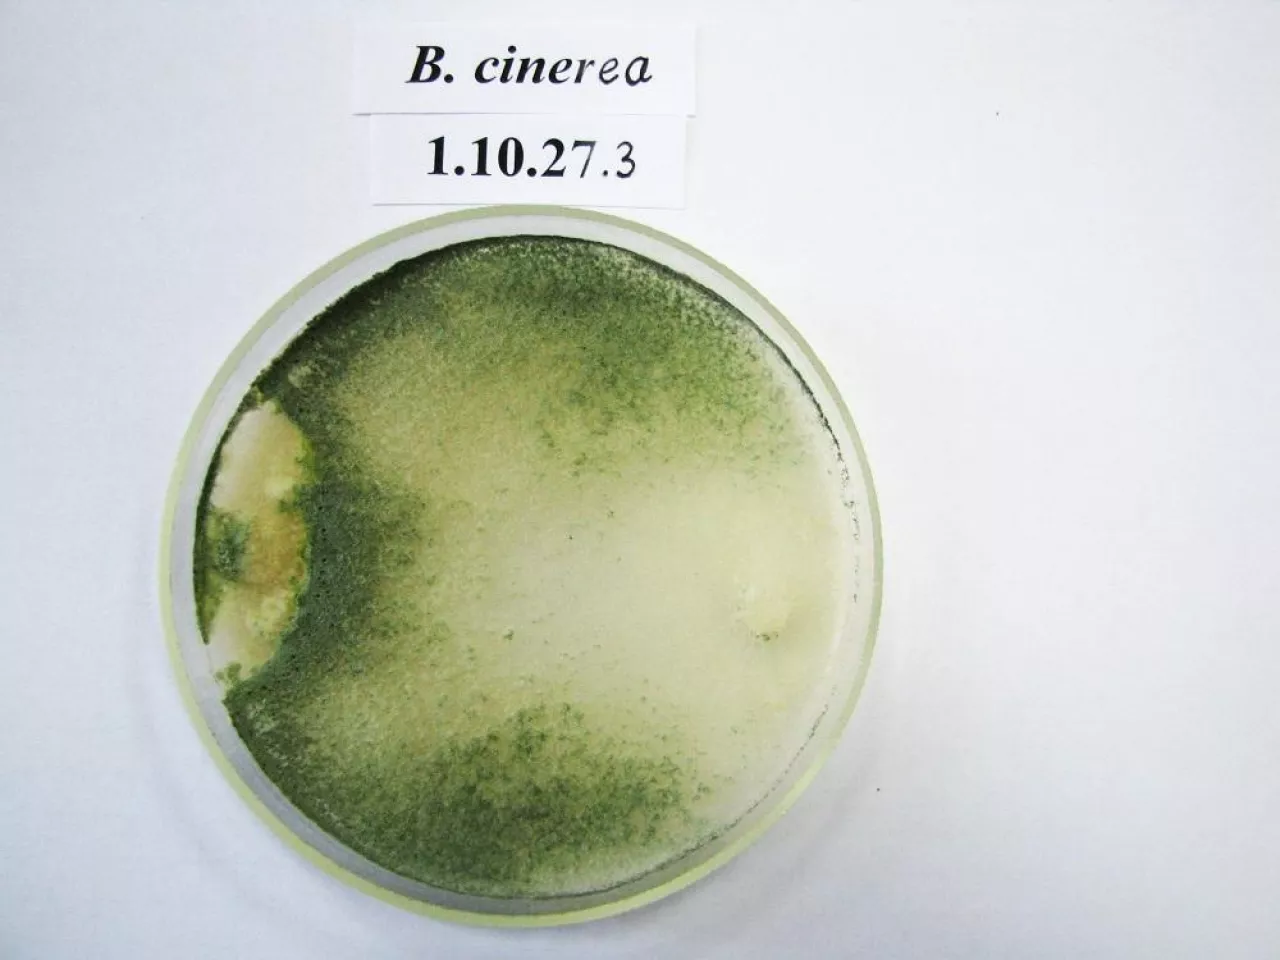
203434

Metody biologiczne, coraz częściej zastępują te chemiczne, które są wycofywane. Trichoderma to grzyby, które możemy stosować doglebowo, jako dodatek do podłoży, do podlewania roślin, do zaprawiania nasion, do moczenia korzeni rozsady, stosować w formie oprysku czy użyć jako dodatku do kompostu.
Dlaczego Trichoderma?
Grzyby Trichoderma są niezwykle powszechne w naturze. Mają zdolność do zasiedlania bardzo zróżnicowanych środowisk. Obficie wytwarzają zarodniki konidialne, dzięki czemu możliwa jest ich masowa produkcja. Mają też zdolność do produkcji przetrwalników – chlamydospor. Modyfikują mikroflorę strefy korzeniowej roślin poprzez intensywną kolonizację korzeni oraz dzięki silnej agresywności wobec patogenicznych grzybów. Zwalczają wiele z nich należących do rodzajów:
- Rhizoctonia;
- Pythium;
- Fusarium;
- Alternaria;
- Sclerotinia;
- Verticillium;
- Botrytis;
- bakterie i wirusy.
Dla przykładu, grzyb T. koningii kolonizuje korzenie cebuli. Strzępki Trichoderma wnikają do epidermy korzenia, niszczą grzybnię patogenu, nie powodując uszkodzeń tkanki rośliny gospodarza. Niektóre szczepy mogą przetrwać na korzeniach nawet 18 miesięcy.
Trichoderma są naturalnie odporne na wiele toksycznych związków – pestycydów (nawet wiele fungicydów). Bardzo szybko odradzają się w glebie po dodaniu subletalnych dawek tych związków.
Co w sprzedaży?
W wielu krajach istnieją komercyjne preparaty stworzone na bazie tych grzybów i są stosowane na szeroką skalę. Na przykład w Brazylii na skalę komercyjną działa 10 wytwórni preparatów opartych na bazie Trichoderma, używanych na szeroką skalę w uprawach fasoli, soi, bawełny, tytoniu, pomidorów, cebuli, truskawki i roślin ozdobnych, również do zaprawiania nasion (T. harzianum T22).
Ocenia się, że stosowanie Trichoderma zmniejsza koszty uprawy o ok. 40%
Na naszym, krajowym rynku można znaleźć tylko nieliczne preparaty zawierające grzyby Trichoderma – węgierski Trifender WP czy holenderski Trianum. W Polsce dotychczas opracowano jeden preparat na bazie T. viride o nazwie Vital Plus, polepszający wzrost roślin oraz ukorzenianie sadzonek truskawek, roślin ozdobnych oraz drzew i krzewów. Problemem w przypadku preparatów zagranicznych jest ich wysoka cena, a także to, że zawierają szczepy wyselekcjonowane w innych niż polskie warunkach klimatycznych. Może to mieć istotny wpływ na ich działanie w naszych warunkach, do których nie są przystosowane.
Z doświadczeń IO
Doświadczenia dowodzą pozytywnego wpływu aplikacji Trichoderma nie tylko na wysokość plonu papryki, ale również na jego jakość. Okazuje się, że grzyb sprzyja też szybszemu i bardziej równomiernemu wybarwianiu owoców.
Dodatni wpływ wykazano też w doświadczeniach z pomidorem – wzrost plonu oraz zawartości likopenu w owocach z poletek szczepionych grzybem.
Plon ogólny i handlowy ziemniaków uprawianych z zastosowaniem Trichoderma były nawet (zależnie od roku) ponad dwukrotnie wyższe niż w kontroli. Stwierdzono też znacznie mniejsze i później występujące nasilenie zarazy ziemniaka na poletkach szczepionych.

fot. Antagonizm Trichoderma wobec Rhizoctonia solani.
W każdym doświadczeniu z zastosowaniem Trichoderma w sałacie średnia masa główek handlowych była wyższa niż w kontroli – w najgorszym wyniku o ok. 100 g, w najlepszym o 340 g.
Jak pokazują doświadczenia Instytutu Ogrodnictwa, warto też zaprawiać grzybami Trichoderma nasiona marchwi i ogórka - wyższy plon ogólny i handlowy, mniejsze porażenie przez alternariozę i mączniaka rzekomego.

fot. Wzrost roślin ogórka w podłożu z Trichoderma.

fot. Grzybnia Trichoderma na podłożu agarowym.
Katarzyna Wójcik na podstawie wykładu dr Magdaleny Szczech z Instytutu Ogrodnictwa w Skierniewicach
01 - Published up: 2026-05-20 17:45:00 - Modified: 2026-05-21 10:07:40 - Feat.: - Title: Marchew zimuje w polu pod słomą do wiosny zamiast w chłodni. Ile to kosztuje rolnika?
02 - Published up: 2026-05-20 12:35:26 - Modified: 2026-05-20 12:35:26 - Feat.: - Title: Ceny marchwi zależą dziś od jakości. Różnice sięgają nawet 1 zł/kg
03 - Published up: 2026-04-29 08:46:24 - Modified: 2026-04-29 08:46:24 - Feat.: - Title: Import marchwi się załamał, ale ceny wystrzeliły. Nawet o 56%
04 - Published up: 2026-04-28 09:25:46 - Modified: 2026-04-28 09:25:46 - Feat.: - Title: Warzywa nie trafiły do sprzedaży, a gospodarstwa liczą straty. Co może zrobić rolnik?
05 - Published up: 2026-04-09 15:57:26 - Modified: 2026-04-09 15:57:26 - Feat.: - Title: Odmiany ogórka na 2026 rok. Co wybrać, żeby dobrze plonował i nadawał się do kiszenia?
01 - Published up: 2022-09-27 22:00:00 - Modified: 2022-10-05 14:17:40 - Feat.: 0 - Title: Jakie wymagania ma minikiwi? Co wiemy o jego uprawie?
02 - Published up: 2022-09-26 22:00:00 - Modified: 2022-09-26 22:00:00 - Feat.: 0 - Title: Lawenda – wszystko, co musisz wiedzieć, zanim posadzisz ją w swoim ogrodzie
03 - Published up: 2022-09-26 22:00:00 - Modified: 2022-09-26 22:00:00 - Feat.: 0 - Title: Tragi Fruit Logistica 2023 - każdy musi tam być!
04 - Published up: 2022-09-26 22:00:00 - Modified: 2022-09-26 22:00:00 - Feat.: 0 - Title: Berry Fest już 3 października – Przegląd alkoholi z owoców jagodowych!
05 - Published up: 2022-09-25 22:00:00 - Modified: 2022-09-25 22:00:00 - Feat.: 0 - Title: Agro Show 2022: uroczyste wręczenie nagród w konkursie "Rolnik - zawód wielkiej wagi"
06 - Published up: 2022-09-22 22:00:00 - Modified: 2022-09-22 22:00:00 - Feat.: 0 - Title: Pomijane w debatach publicznych założenie WPR – gwarantowane godziwe ceny dla producentów warzyw i owoców
07 - Published up: 2022-09-22 22:00:00 - Modified: 2022-09-22 22:00:00 - Feat.: 0 - Title: Agro Show 2022 - relacja dzień pierwszy!
08 - Published up: 2022-09-22 22:00:00 - Modified: 2022-09-22 22:00:00 - Feat.: 0 - Title: Koniec naborów do Natura 2000!
09 - Published up: 2022-09-21 22:00:00 - Modified: 2022-09-21 22:00:00 - Feat.: 0 - Title: T.B.Fruit - czy należne pieniądze trafią do poszkodowanych?
10 - Published up: 2022-09-21 22:00:00 - Modified: 2022-09-21 22:00:00 - Feat.: 0 - Title: Wygrajmy razem przyszłość Szymka
11 - Published up: 2022-09-21 22:00:00 - Modified: 2022-09-21 22:00:00 - Feat.: 0 - Title: "Rozwijajmy to, co wspiera produkcję rolną" - agrochemiczne spółki rozwijają globalną tożsamość marki
12 - Published up: 2022-09-20 22:00:00 - Modified: 2022-09-20 22:00:00 - Feat.: 0 - Title: Święto Buraczka w Woli Łagiewnickiej
13 - Published up: 2022-09-20 22:00:00 - Modified: 2022-09-20 22:00:00 - Feat.: 0 - Title: Krajowi producenci zużywający największe ilości gazu i energii elektrycznej do produkcji mają otrzymać wsparcie finansowe
14 - Published up: 2022-09-19 22:00:00 - Modified: 2022-09-19 22:00:00 - Feat.: 0 - Title: Materiał kwalifikowany - klucz do sukcesu? - Ocena PIORiN
15 - Published up: 2022-09-19 22:00:00 - Modified: 2022-09-19 22:00:00 - Feat.: 0 - Title: Choć nie są obfite, zbiory winogron zostały w dużej mierze ‘uratowane‘ w UE
16 - Published up: 2022-09-19 22:00:00 - Modified: 2022-10-05 14:23:16 - Feat.: 0 - Title: Zestaw ciężarowy przewożący buraki wpadł do rowu pod Środą Wielkopolską
17 - Published up: 2022-09-15 22:00:00 - Modified: 2022-09-15 22:00:00 - Feat.: 0 - Title: Dyskryminacja Polski? – Twarde stanowisko w sprawie ŚOR
18 - Published up: 2022-09-15 22:00:00 - Modified: 2022-09-15 22:00:00 - Feat.: 0 - Title: Kontrowersyjna ustawa o biopaliwach- rząd się wycofuje
19 - Published up: 2022-09-15 22:00:00 - Modified: 2022-09-15 22:00:00 - Feat.: 0 - Title: Pogoda długo terminowa – Grudzień ekstremalnie ciepły?
20 - Published up: 2022-09-14 22:00:00 - Modified: 2022-09-14 22:00:00 - Feat.: 0 - Title: Czas na dochód gwarantowany dla każdego mieszkańca? 1 300 złotych na rękę!
01 - Published up: 2022-09-27 22:00:00 - Modified: 2022-10-05 14:17:40 - Feat.: 0 - Title: Jakie wymagania ma minikiwi? Co wiemy o jego uprawie?
02 - Published up: 2022-09-26 22:00:00 - Modified: 2022-09-26 22:00:00 - Feat.: 0 - Title: Lawenda – wszystko, co musisz wiedzieć, zanim posadzisz ją w swoim ogrodzie
03 - Published up: 2022-09-26 22:00:00 - Modified: 2022-09-26 22:00:00 - Feat.: 0 - Title: Tragi Fruit Logistica 2023 - każdy musi tam być!
04 - Published up: 2022-09-26 22:00:00 - Modified: 2022-09-26 22:00:00 - Feat.: 0 - Title: Berry Fest już 3 października – Przegląd alkoholi z owoców jagodowych!
05 - Published up: 2022-09-25 22:00:00 - Modified: 2022-09-25 22:00:00 - Feat.: 0 - Title: Agro Show 2022: uroczyste wręczenie nagród w konkursie "Rolnik - zawód wielkiej wagi"
06 - Published up: 2022-09-22 22:00:00 - Modified: 2022-09-22 22:00:00 - Feat.: 0 - Title: Pomijane w debatach publicznych założenie WPR – gwarantowane godziwe ceny dla producentów warzyw i owoców
07 - Published up: 2022-09-22 22:00:00 - Modified: 2022-09-22 22:00:00 - Feat.: 0 - Title: Agro Show 2022 - relacja dzień pierwszy!
08 - Published up: 2022-09-22 22:00:00 - Modified: 2022-09-22 22:00:00 - Feat.: 0 - Title: Koniec naborów do Natura 2000!
09 - Published up: 2022-09-21 22:00:00 - Modified: 2022-09-21 22:00:00 - Feat.: 0 - Title: T.B.Fruit - czy należne pieniądze trafią do poszkodowanych?
10 - Published up: 2022-09-21 22:00:00 - Modified: 2022-09-21 22:00:00 - Feat.: 0 - Title: Wygrajmy razem przyszłość Szymka
11 - Published up: 2022-09-21 22:00:00 - Modified: 2022-09-21 22:00:00 - Feat.: 0 - Title: "Rozwijajmy to, co wspiera produkcję rolną" - agrochemiczne spółki rozwijają globalną tożsamość marki
12 - Published up: 2022-09-20 22:00:00 - Modified: 2022-09-20 22:00:00 - Feat.: 0 - Title: Święto Buraczka w Woli Łagiewnickiej
13 - Published up: 2022-09-20 22:00:00 - Modified: 2022-09-20 22:00:00 - Feat.: 0 - Title: Krajowi producenci zużywający największe ilości gazu i energii elektrycznej do produkcji mają otrzymać wsparcie finansowe
14 - Published up: 2022-09-19 22:00:00 - Modified: 2022-09-19 22:00:00 - Feat.: 0 - Title: Materiał kwalifikowany - klucz do sukcesu? - Ocena PIORiN
15 - Published up: 2022-09-19 22:00:00 - Modified: 2022-09-19 22:00:00 - Feat.: 0 - Title: Choć nie są obfite, zbiory winogron zostały w dużej mierze ‘uratowane‘ w UE
16 - Published up: 2022-09-19 22:00:00 - Modified: 2022-10-05 14:23:16 - Feat.: 0 - Title: Zestaw ciężarowy przewożący buraki wpadł do rowu pod Środą Wielkopolską
17 - Published up: 2022-09-15 22:00:00 - Modified: 2022-09-15 22:00:00 - Feat.: 0 - Title: Dyskryminacja Polski? – Twarde stanowisko w sprawie ŚOR
18 - Published up: 2022-09-15 22:00:00 - Modified: 2022-09-15 22:00:00 - Feat.: 0 - Title: Kontrowersyjna ustawa o biopaliwach- rząd się wycofuje
19 - Published up: 2022-09-15 22:00:00 - Modified: 2022-09-15 22:00:00 - Feat.: 0 - Title: Pogoda długo terminowa – Grudzień ekstremalnie ciepły?
20 - Published up: 2022-09-14 22:00:00 - Modified: 2022-09-14 22:00:00 - Feat.: 0 - Title: Czas na dochód gwarantowany dla każdego mieszkańca? 1 300 złotych na rękę!